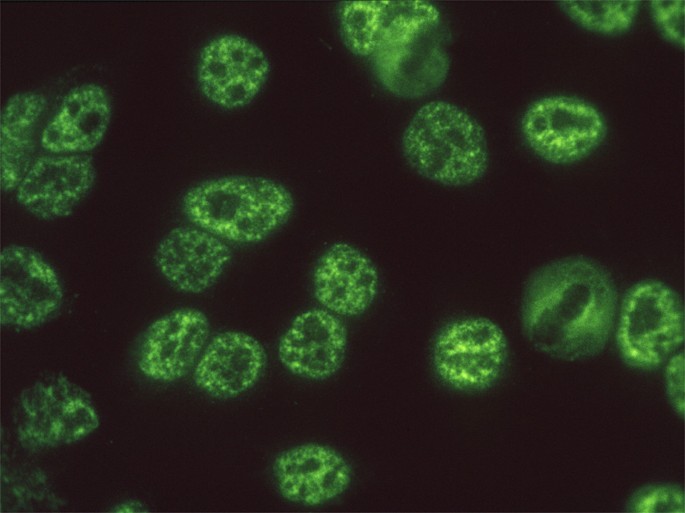

Pcna Ana Pattern
2

Pleomorphic Nuclear Staining Pcna Download Scientific Diagram
Http Citeseerx Ist Psu Edu Viewdoc Download Doi 10 1 1 793 6149 Rep Rep1 Type Pdf
Https Wwwn Cdc Gov Nchs Data Nhanes3 45a Ssnh3ana Htm
Https Www Mblbio Com E Ivd Images Mbl Ana All E Pdf

Ana Mixed Pattern University Of Birmingham


Report Of The First International Consensus On Standardized Nomenclature Of Antinuclear Antibody Hep 2 Cell Patterns 2014 2015 Abstract Europe Pmc

Variability In The Recognition Of Distinctive Immunofluorescence Patterns In Different Brands Of Hep 2 Cell Slides

Identification Of Specific Antinuclear Antibodies In Dogs Using A Line Immunoassay And Enzyme Linked Immunosorbent Assay Sciencedirect

Proliferating Cell Nuclear Antigen Wikipedia

Portrait Of The Hep2 Cell The Pet Of Immunofluorescence Professionals Orgentec Autoimmunity Blog
Https Encrypted Tbn0 Gstatic Com Images Q Tbn 3aand9gcrfwncekgy1joq4pubfya Oc9ailp5m5 8 Qsp4jkjk1vxok A Usqp Cau

Iif On Hep2 Cells Speckled Pattern Of Varying Intensity Anti Pcna Download Scientific Diagram

Proliferating Cell Nuclear Antigen Pcna Pattern Cell Cycle Dependent Only Detected In Cells That Are Preparing For Mitosis R Cell Cycle Mitosis Positivity

Presentation Of Autoantibody To Proliferating Cell Nuclear Antigen In Patients With Chronic Hepatitis B And C Virus Infection Annals Of The Rheumatic Diseases
Https Www Mblbio Com E Ivd Images Mbl Ana All E Pdf
.jpg)
Ana Mixed Pattern University Of Birmingham

Pcna Wikipedia
Http Onlinelibrary Wiley Com Doi 10 1002 Jcla 20391 Pdf

Pdf Update On Antinuclear Antibody Ana Screening And Pattern Differentiation Dissecting Pleomorphic Patterns Pcna Sg2na Ac 30 And Pseudo Pcna Patterns

Portrait Of The Hep2 Cell The Pet Of Immunofluorescence Professionals Orgentec Autoimmunity Blog
Antinuclear Antibodies Defining Autoimmunity Pathways Arthritis Research Therapy Full Text

Figure 2 From Antinuclear Antibodies Ana Patterns In Paraneoplastic Cerebellar Degeneration During The Course Of Disease And Treatment Protocols A Case Report Semantic Scholar

Pdf Update On Antinuclear Antibody Ana Screening And Pattern Differentiation Dissecting Pleomorphic Patterns Pcna Sg2na Ac 30 And Pseudo Pcna Patterns

Autoantibodies And Biomarkers Diagnostic Aspects Springerlink
.jpg)
Ana Mixed Pattern University Of Birmingham
Detection In Whole Blood Of Autoantibodies For The Diagnosis Of Connective Tissue Diseases In Near Patient Testing Condition

30 Best Ana Patterns Ifa Images Ana Anti Nuclear Antibody Pattern

Frontiers Antinuclear Antibodies With A Homogeneous And Speckled Immunofluorescence Pattern Are Associated With Lack Of Cancer While Those With A Nucleolar Pattern With The Presence Of Cancer Medicine

Proliferating Cell Nuclear Antigen Wikipedia

The Use Of Laboratory Tests In The Diagnosis Of Sle Journal Of Clinical Pathology
Https Wwwn Cdc Gov Nchs Data Nhanes3 45a Ssnh3ana Htm
Http Citeseerx Ist Psu Edu Viewdoc Download Doi 10 1 1 793 6149 Rep Rep1 Type Pdf

Hep 2 Cell Cycle Related Patterns University Of Birmingham

Ana Quiz University Of Birmingham

Predictive Value Of Antinuclear Antibodies In Autoimmune Diseases Classified By Clinical Criteria Analytical Study In A Specialized Health Institute One Year Follow Up Sciencedirect

Proliferating Cell Nuclear Antigen Wikiwand

Autoimmune Diagnostics Chemgapedia

Isolated Anti Dfs70 Autoantibodies Negative Disease Correlation With A Positive Impact Medical Laboratory Observer

Centromere Staining Download Scientific Diagram

Dynamics Of Plant Dna Replication Based On Pcna Visualization Scientific Reports

Lit Rheumatic Disease Trifold By Business Network Designs Issuu

Portrait Of The Hep2 Cell The Pet Of Immunofluorescence Professionals Orgentec Autoimmunity Blog

Hep 2 Mitotics Related Ab University Of Birmingham
.jpg)
Ana Mixed Pattern University Of Birmingham

Ana The Misunderstood Lab Test

Assessment Of Antinuclear Antibodies By Indirect Immunofluorescence Assay Report From A Survey By The American Association Of Medical Laboratory Immunologists In Clinical Chemistry And Laboratory Medicine Cclm Volume 58 Issue 9 2020
.jpg)
Hep 2 Mitotics Related Ab University Of Birmingham

Indian J Pathol Microbiol Mobile Full Site Home Toc Xml Version 1 0 Indian Journal Of Pathology And Microbiology Vol 53 No 3 July September 2010 Pp 427 432 Your Are Viewing Optimised Page For Portable Devives To See Detailed Version

Interpretation Of Autoantibodies In Rheumatological Diseases Revista Colombiana De Reumatologia English Edition

V Brazilian Consensus Guidelines For Detection Of Anti Cell Autoantibodies On Hep 2 Cells

Frontiers Report Of The First International Consensus On Standardized Nomenclature Of Antinuclear Antibody Hep 2 Cell Patterns 2014 2015 Immunology

Antibody Reactivity Against M2 Pcna Rib Cenp B And Pm Scl In The Download Scientific Diagram

Ana Patterns

Frontiers Report Of The First International Consensus On Standardized Nomenclature Of Antinuclear Antibody Hep 2 Cell Patterns 2014 2015 Immunology
Https Encrypted Tbn0 Gstatic Com Images Q Tbn 3aand9gcsecde5shoilk94hsqotqmd3cmkvzgelyhksmtfmfgkneg4e 4k Usqp Cau
Https Www Mblbio Com E Ivd Images Mbl Ana All E Pdf

Iif On Hep2 Cells Speckled Pattern Of Varying Intensity Anti Pcna Download Scientific Diagram

Frontiers Report Of The First International Consensus On Standardized Nomenclature Of Antinuclear Antibody Hep 2 Cell Patterns 2014 2015 Immunology
Https Wwwn Cdc Gov Nchs Data Nhanes3 45a Ssnh3ana Htm
Https Www Longdom Org Open Access Evaluation Of Diagnostic Significance And Cost Effectiveness Of Elisa Andifa For The Diagnosis Of Autoimmune Disorders 1745 7580 1000155 Pdf

Ana Patterns

Pleomorphic Nuclear Staining Pcna Download Scientific Diagram

Ana The Misunderstood Lab Test

Ana Patterns
2

Expression Patterns And Cell Cycle Profiles Of Pcna Mcm6 Cyclin D1 Cyclin A2 Cyclin B1 And Phosphorylated Histone H3 In The Developing Mouse Retina Barton 2008 Developmental Dynamics Wiley Online Library

8 Best Ana Patterns Images Ana Anti Nuclear Antibody Nuclear Membrane

Antinuclear Antibodies Ana Patterns In Paraneoplastic Cerebellar Degeneration During The Course Of Disease And Treatment Protocols A Case Report Sciencedirect
Https Onlinelibrary Wiley Com Doi Pdf 10 1002 Art 1780260204
.jpg)
Hep 2 Cell Cycle Related Patterns University Of Birmingham

Ana Patterns

Personalized Medicine In Rheumatology The Paradigm Of Serum Autoantibodies Springerlink
Https Www Euroimmun Com Documents Indications Autoimmunity Rheumatology Ana Fa 1510 I Uk B Pdf

Pleomorphic Nuclear Staining Pcna Download Scientific Diagram
Https Www Pathologyjournal Rcpa Edu Au Article S0031 3025 20 30402 5 Pdf

Dynamics Of Plant Dna Replication Based On Pcna Visualization Scientific Reports

Anti Pseudo Pcna Type 1 Anti Sg2na Pattern Track Down Cancer Not Sle Sciencedirect

Comparative Analysis Of Antinuclear Antibody And Antinuclear Antibody Spectrum American Laboratory

Pleomorphic Nuclear Staining Pcna Download Scientific Diagram

Portrait Of The Hep2 Cell The Pet Of Immunofluorescence Professionals Orgentec Autoimmunity Blog
Https Encrypted Tbn0 Gstatic Com Images Q Tbn 3aand9gcr3p3oae0xogciudsb8iwbxcttmsswtmuiglivdc6dwvdfd6td Usqp Cau

Hep 2 Mitotics Related Ab University Of Birmingham

Antinuclear Antibodies Musculoskeletal Key

Antinuclear Antibodies Antibodies To Dna Histones And Nucleosomes Sciencedirect

Isolated Anti Dfs70 Autoantibodies Negative Disease Correlation With A Positive Impact Medical Laboratory Observer

Homogeneous And Pcna Patterns Ana Module Pattern

V Brazilian Consensus Guidelines For Detection Of Anti Cell Autoantibodies On Hep 2 Cells Springerlink

Ana Patterns
.jpg)
Hep 2 Cell Cycle Related Patterns University Of Birmingham

Antibody Titre And Final Diagnosis In The 29 Patients With Anti Pcna Download Table
Https Wwwn Cdc Gov Nchs Data Nhanes3 45a Ssnh3ana Htm

Connective Tissue Diseases Euroimmun Ag

Antinuclear Antibodies Defining Autoimmunity Pathways Arthritis Research Therapy Full Text
Https Immunoconcepts Com Wp Content Uploads 2015 12 Ana Fa 2k En Pdf

Pdf The Clinical Significance Of Autoantibodies To The Proliferating Cell Nuclear Antigen Pcna Carol Peebles Academia Edu

Ana Quiz University Of Birmingham

Ana Patterns
Https Www Euroimmun Com Documents Indications Autoimmunity Rheumatology Ana Fa 1510 I Uk B Pdf
Https Www Mblbio Com E Ivd Images Mbl Ana All E Pdf
Https Www Mblbio Com E Ivd Images Mbl Ana All E Pdf

Autoimmune Diagnostics Chemgapedia
Https Www Euroimmun Ch Fileadmin Euroimmun Pdf News Article Ha 1500 L Uk D Pdf



